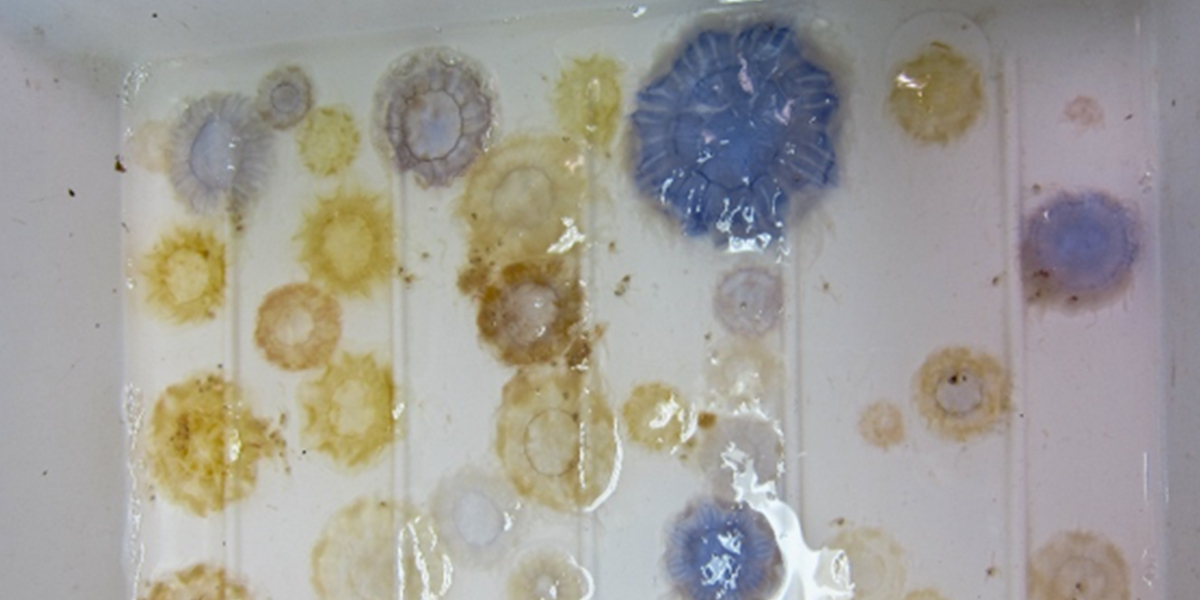
<i>Cyanea lamarckii</i> and <i>Cyanea capillata</i> jellyfish mixture, caught on the North Sea in 2012. Photo: Lodewijk van Walraven

Cyanea spp.
Fear of jellyfish stings is quite justified in many areas of the world where species live whose stings can cause severe skin lesions, or worse. In the Netherlands however, most species of jellyfish are quite harmless, as long as you don’t stick them in your eye or have them touch places of your body where your skin is very thin.

The exception to the rule
The exception to the rule are the species of the genus Cyanea, of which you can find two species in Dutch waters; the lion’s mane jellyfish Cyanea capillata and the blue jellyfish Cyanea lamarckii. Both of these species can cause painful stings, especially Cyanea capillata.
This is also an excellent example of why it is generally a bad idea to name a species after their colour. Cyanea capillata is called either 'gele haarkwal' or 'rode haarkwal' (yellow or red jellyfish) in Dutch, which quite accurately describes their colour range. Cyanea lamarckii however, is called 'blauwe haarkwal' (blue jellyfish). While this species can have a beautiful blue coloration, yellow and white individuals are very common. The below photo is a mixture of Cyanea capillata and Cyanea lamarckii I caught on the North Sea in 2012 from NIOZ RV Pelagia. Lots of yellow jellyfish, of which most are actually the 'blue jellyfish' Cyanea lamarckii.
Differences
Well then, how do you distinguish between the two species? For this you have to look very closely at the muscle filaments, which lay in a circular pattern on the bell. In Cyanea capillata these muscle filaments have rows of small spots perpendicular to the muscle filaments, which are actually extensions of the gastric system. These are absent in Cyanea lamarckii (see on the right).
The large colour variation in Cyanea lamarckii fascinated NIOZ researcher S. M. (Gré) van der Baan, who studied seasonal abundance and species composition of jellyfish in the early 1960s by analysing catches taken from the 'Texel' lightvessel. A lightvessel was basically a floating lighthouse. The crew of the 'Texel' lightvessel collected samples of fish larvae and jellyfish for NIOZ researchers such as Creutzberg and van der Baan, from 1961 – 1966. The catch of the big plankton nets was transported to the institute in milk jugs filled with formaldehyde using pilot boats.
Seasonal pattern
Van der Baan found that there was a seasonal pattern in the colour variation; medusae caught in winter and spring were colourless white – yellow, while medusae caught in summer were bright blue. She hypothesised that this colour variation might suggest the existence of two different populations of Cyanea lamarckii with different strobilation (release of juvenile jellyfish) timing; a 'pale population' spawning in winter and a 'blue population' strobilating in spring/summer. This hypothesis has yet to be confirmed, as polyps of the species have not been observed in the wild.
While Cyanea lamarckii does not really get bigger than a dinner plate, Cyanea capillata is known as the largest species of jellyfish and possibly the longest animal species worldwide, with tentacle lengths of 37 meters reported. Luckily for the Dutch, Lion’s mane jellyfish Cyanea capillata appears to be a cold water species that is being seen less and less frequently on our shores as southern North Sea temperatures are rising.
References
Van der Baan, S.M. 1980. The seasonal occurrence of scyphomedusa in surface waters near the `Texel’ lightvessel. NIOZ report 1980–8.


